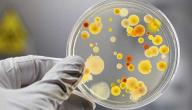
مواد تخصص الأحياء

علم الأحياء
يُعرف علم الأحياء بأنّه الدراسة التي يقوم بها البيولوجيون لبنية الكائنات الحية ووظائفها ونموها وأصلها وتطوّرها وتوزيعها، وللتمكن من دراسة علم الأحياء لابدّ من القيام بدراسات شاملة حول وظائف الأعضاء والبيئة، ولقد تمّ القيام بدراسة الحيوانات من قبل البشر الأوائل، وتشمل الدراسات التي في علم الأحياء كلًا من دراسة المواد المادية التي تشكل الكائنات الحية ودراسة النبات والوحدات الخلوية الأساسية للكائنات الحية وتفاعل الكائنات الحية مع بيئاتها وعلم الوراثة والجزيئات البيولوجية ووظائف الكائنات الحية وأجزائها وسلوك الحيوان، وغالبًا ما يتمّ ربط دراسة علم الأحياء مع العلوم الأخرى كالرياضيات والهندسة والعلوم الاجتماعية، وفي ما يأتي سيتمّ الحديث عن علم الأحياء الدقيقة.[١]
علم الأحياء الدقيقة
يعرف علم الأحياء الدقيقة بأنّه العلم الذي يختصّ بدراسة الكائنات الحية الدقيقة التي لا تُرى بالعين المجردة وتشمل الكائنات أحادية الخلية ومتعددة الخلايا وكذلك تلك التي تفتقر للخلايا، وتشمل هذه الدراسات العديد من التخصصات الفرعية كعلم الفيروسات والطفيليات والفطريات والبكتيريا، كما يمكن أن تتسبب بعض أنواع المخلوقات الدقيقة والتي لا تُرى بالعين المجردة بأمراض خطيرة جدًا كالأنواع التي تطفو بالهواء وتدخل الجسم عبر الأنف والفم، وتنتشر الأحياء الدقيقة في جميع أجزاء الكون وحتى في أنسجة النباتات ولحوم الحيوانات، وتعتمد دراسة الأحياء الدقيقة بشكلٍ كبير على المجاهر التي تستخدم في فحص الحمض النووي لهذه الأحياء وأجزائها وغيرها العديد من خصائص هذه الكائنات، كما يمكن استخدام هذه الكائنات في العديد من العمليات المفيدة كالتخمير الصناعي وإنتاج المضادات الحيوية وغيرها العديد.[٢]
أنواع الأحياء الدقيقة
بعد التعرّف على علم الأحياء الدقيقة سيتمّ الحديث عن أنواع الأحياء الدقيقة، إذ يتم تقسيم الأحياء الدقيقة إلى عدّة تصنيفات رئيسة، حيث تُساعد هذه التقسيمات في تسهيل دراسة هذه الأحياء وتأثيرها على البيئة والكائنات الحية الأخرى، وفي ما يأتي سيتمّ الحديث عن بعض أنواع الأحياء الدقيقة:[٣]
- البكتيريا: تتميز هذه الكائنات بأنّها كائنات وحيدة الخلية تفتقر للنواة المحاطة بغشاء نووي، وتمتلك هذه الكائنات أشكال مختلفة مثل الأشكال الكروية والعصوية والحلزونية.
- الطحالب: وهي من الكائنات الدقيقة وحيدة الخلية، حيث تقوم الطحالب بعملية التمثيل الضوئي وتمتلك جدران خلايا صلبة، وعادةً ما تتواجد هذه الكائنات في التربة الرطبة والبيئات المائية.
- الفطريات: وهي كائنات حية حقيقية النواة تمتلك جدران خلايا صلبة، وتفتقر إلى الكلوروفيل وبالتالي لا يمكنها القيام بعملية التمثيل الضوئي، وقد تكون أحادية الخلية أو متعددة الخلايا.
- الكائنات الأولية: وهي كائنات دقيقة أحادية النواة، وتتواجد هذه الكائنات بعدة أشكال إما بيضاوية أو كروية أو غيرها، وتفتقر الكائنات الأولية إلى جدران الخلايا.
- الفيروسات: تتوزع الفيروسات بشكلٍ واسع في الطبيعة، وتعتمد الفيروسات على الخلايا المضيفة للقيام بالوظائف الحيوية، ولا يمكن رؤية الفيروسات إلا بالمجهر الإلكتروني.
- البريونات: تتميّز البريونات بعدم امتلاكها لأي مواد وراثية، وتعدّ هذه الكائنات الدقيقة من مسببات الأمراض المختلفة كمرض جنون البقر وغيره العديد.
المراجع[+]
- ↑ "What Is Biology?", www.livescience.com, Retrieved 04-01-2020. Edited.
- ↑ "Microbiology", www.wikiwand.com, Retrieved 04-01-2020. Edited.
- ↑ "Microbiology", www.britannica.com, Retrieved 04-01-2020. Edited.